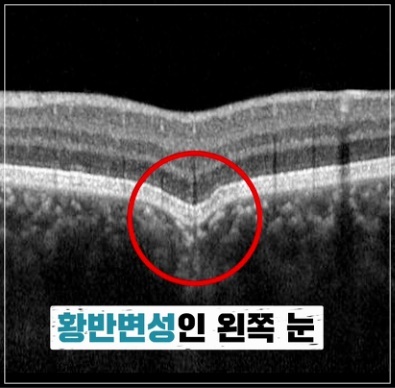
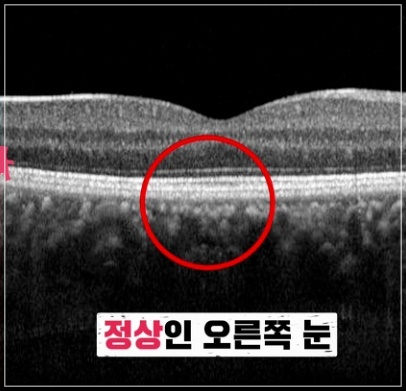

국내 3대 실명 질환 중 하나가 황반변성입니다. 황반변성은 눈 안쪽 망막 중심부에 위치한 황반에 변화가 생기면서 시력이 떨어지는 질환으로 아직 발병 원인이 정확히 알려지지 않았지만, 빠른 노화가 주원인으로 꼽힙니다.




황반변성으로 손상된 세포는 되살릴 방법이 없어 예방이 중요하므로 황반변성의 원인, 치료법에 대해 다음글에서 확인하시기 바랍니다.
황반변성의 원인
황반변성의 원인은 아직 명확하게 규명되지 않았지만, 노화로 인해 황반 부위의 신경세포가 서서히 퇴화하는 것을 주원인으로 본다. 황반변성이 일어나는 망막과 맥락막 조직은 우리 몸에서 가장 왕성한 혈액이 흐르는 조직으로 그 만큼 산화 스트레스도 많이 발생한다.




황반변성의 종류
황반변성은 건성황반변성과 습성황반변성, 두 종류로 나뉩니다. 전체 황반변성의 80~90%를 차지하는 ‘건성 황반변성’의 경우 초기에는 증상이 거의 없고 진행이 느리며 심각한 시력 상실을 유발하지 않습니다.
반면 ‘습성 황반변성’은 시력 저하가 매우 급격히 진행되며, 치료하지 않고 그대로 방치하면 수개월 내에 실명에 이를 수 있습니다.



황반변성의 증상
황반변성 초기에는 뚜렷한 이상을 찾기 어렵다. 그러다 병이 진행되면 사물의 형태를 구별하는 능력이 떨어지고 부엌과 욕실의 타일, 건물 등의 선이 물결치듯 굽어보이는 증상이 나타납니다.



이 경우 바둑판 모양의 직선이 그려져 있는 ‘암슬러 격자’를 이용한 자가진단으로 황반변성을 의심해 볼 수 있습니다.
황반변성의 치료
흡연을 하는 사람들은 금연을 권장하거나 조금씩 코를 줄여나가는 것이 중요하고 자외선에 도움이 되는 선글라스나 선캡 등을 착용하여 자외선 예방에 도움을 줍니다.

그리고 열량이 높거나 콜레스테롤이 높고, 고혈압을 유발하는 패스들 식품이나 지방이 많은 음식은 줄이고 녹황색 채소나 등 푸른 생선 등을 섭취하여 식생활을 개선해나가는 것이 중요합니다.




최근댓글